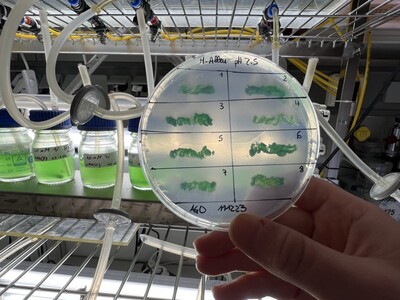
Mikroalgen mit großer Umweltwirkung | © Helmut Stapel Mikroalgen mit großer Umweltwirkung | © Helmut Stapel

Alle Artikel
Der Mensch braucht Sauerstoff, um zu leben. Bei Mikroalgen ist das anders herum. Sie nutzen Kohlendioxid, um zu wachsen.

Rest-Eis aus der Fisch- und Lebensmittelproduktion bietet ein großes Potenzial an wieder nutzbarer Energie, wie die Praxisphase eines Projektes des Technologie-Transferzentrums Bremerhaven (ttz) und der Fischereihafen-Betriebsgesellschaft (FBG) gezeigt hat.

Ein Meilenstein für erneuerbare Energien im Land Bremen: Laut dem Melderegister der Bundesnetzagentur sind erstmals Photovoltaik-Anlagen mit einer Gesamtleistung von mehr als 100.000 Kilowatt-Peak (kWp) in Betrieb.

In Deutschland werden circa 14 Prozent des Stromverbrauchs für die Erzeugung von Kälte eingesetzt. Davon ist Klimakälte für Einzelhandel, Büro oder öffentliche Gebäude mittlerweile allen bekannt. Doch wo liegen die verborgenen Kälteanwendungen und – im Interesse des Klimaschutzes – vor allem deren Einsparpotenziale?

Abschlussveranstaltung der Workshopreihe „Gemeinsam Stadt gestalten mit kooperativen Prozessen“

In Bremerhaven wird an einer autonom fahrenden Fähre geforscht.